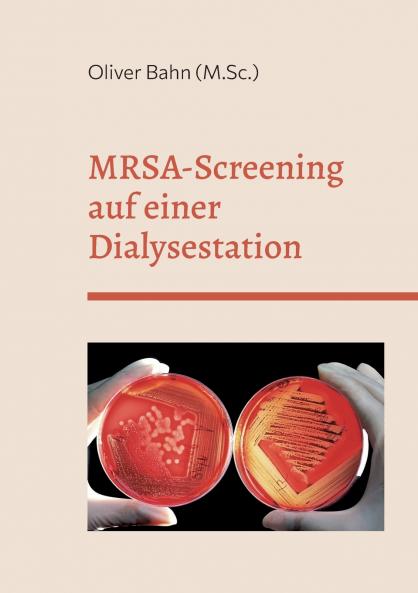
MRSA-Screening auf einer Dialysestation

German
Paperback
₹880
₹913
3.61% OFF
(All inclusive*)
Delivery Options
Please enter pincode to check delivery time.
*COD & Shipping Charges may apply on certain items.
Review final details at checkout.
Looking to place a bulk order? SUBMIT DETAILS
About The Book
Description
Author
-MRSA-Studie auf einer Dialysestation-Das Auftreten von MRSA hat in den letzten Jahren für viel Aufmerksamkeit im Gesundheitswesen gesorgt. Dies hat auch maßgebliche Auswirkungen auf die tägliche Arbeit in der Dialyse. Initiiert vom MRE-Netzwerk Rhein-Main wurde die Prävalenz vonMRSA einer Teilstationären Dialysestation erhoben.
Delivery Options
Please enter pincode to check delivery time.
*COD & Shipping Charges may apply on certain items.
Review final details at checkout.
Details
ISBN 13
9783756843343
Publication Date
-01-12-2022
Pages
-50
Weight
-74 grams
Dimensions
-148x210x2.63 mm